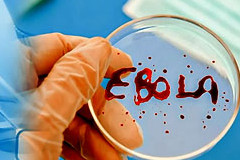
Изображение

В США зафиксирована вторая смерть от вируса Эбола
-
Редакция
В США зафиксирована вторая смерть от вируса Эбола
Хирург Мартин Сэлиа, заразившийся в Сьерра-Леоне вирусом Эбола (БВВЭ) и доставленный на лечение в США, скончался. Об этом сообщают информагентства со ссылкой на представителей больницы.
Читать новость на сайте...
Кто сейчас на конференции
Сейчас этот форум просматривают: нет зарегистрированных пользователей и 0 гостей

